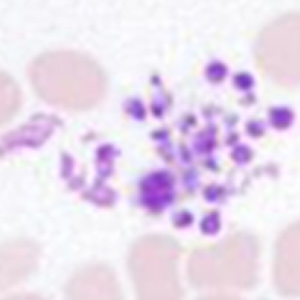

CAL 9000
Maximizing Efficiency Through One Process Solution
ALL IN
 Solution for Hematology Analysis
Solution for Hematology Analysis
Maximizing Efficiency Through One Process Solution
As one of the most crucial components of clinical laboratories, the hematology analysis line receives a significant performance boost when empowered by premium automation technologies. From the pre-analytical to post-analytical phases, encompassing sample reception to results reporting, these automation technologies allow laboratories to scale operations and focus staff on high-level tasks while consistently delivering accurate results.

{{findIndex(1)[0].title}}
{{findIndex(1)[0].class}}
{{findIndex(2)[0].title}}
{{findIndex(2)[0].class}}
{{findIndex(3)[0].title}}
{{findIndex(3)[0].class}}
{{findIndex(4)[0].title}}
{{findIndex(4)[0].class}}
{{findIndex(5)[0].title}}
{{findIndex(5)[0].class}}
{{findIndex(6)[0].title}}
{{findIndex(6)[0].class}}
{{item.title}}

The labXpert Software Optimizes Following Functions to Simplify Your Workflow for Data Analysis
- Improved re-exam criteria function with multi-conditions setup
- Auto-validation for normal samples
- More intuitive interface to review and validate pathological samples
- Free of charge multi-station remote validation

H-120 Automated Glycohemoglobin Analyzer
The H-120 offers the gold-standard High Performance Liquid Chromatography (HPLC) method, ensuring long-term precision with a coefficient of variation (CV) ≤ 1%. The standard mode, operating at a high throughput of 120 tests per hour, flags 6 hemoglobin variant interferences (HbC/HbD/HbS/HbE/HbJ-Bangkok/HbUbe-2) as "Suspected variants" and automatically switches to variant mode to provide a more reliable result that exclude variant interferences (HbC/HbD/HbS/HbE).

MC-80 Automated Digital Cell Morphology Analyzer
The MC-80 delivers ultra-high resolution microscopic imaging, recreating true-to-life visuals with exceptional clarity. Leveraging advanced Multi-Layer Fusion technology, it precisely reconstructs cellular pathological features enabling more accurate early screening for blood disorders and infectious diseases.

SC-120 Auto Slide Maker & Stainer
Mindray provides original slides to ensure quality of blood smears and reliable performance of SC-120. It supports multiple staining protocol, such as Wright stain, Wright-Giemsa stain, and May-Grunwald-Giemsa stain.

BC-7600 Series Auto Hematology Analyzer
BC-7600 Series Auto Hematology Analyzers provide comprehensive solutions for complete blood count (CBC), differential white blood cell count (DIFF), hematological malignant cells, low-value WBC/PLT, PLT clumps, etc. They also support the analysis of body fluids. It provides NRBC results in every CBC + DIFF test without additional reagents. To enhance abnormal platelet and WBC detection accuracy, the patented PLT-8X and WBC-3X multiple sampling methods are employed for low PLT value and low WBC value sample analysis, respectively.
Reliable CBC+ESR Results With Excellent Efficiency
Based on photometric method, BC-7600 Series can provide reliable CBC+ESR result in the single instrument within 40 seconds.

TM-1000 Sample Processing System
- Dispense-and-go for sample loading, scanning, and registration
- One-click sample access and re-analysis
- Intelligent sample dispatch and priority management
- Automatically archive samples following customized settings


CR-30[H] Concentrated Reagent Delivery System
- Replace reagent once a week*
- Replace DCT diluent without interrupting workflow
- Directly provide deionized water for SC-120
- Reliable and stable performance of diluted reagent
* The frequency may change according to different scenario
Close


Early Diagnostic &
Intelligent Reflex

PLT Clump?

Infected RBC?

Abn. Lymph/blast?
BC-7600 Series
Automatic Slide
Making & Stain
SC-120
Morphology Analysis

Plasmodium

Abnormal promyelocytes
PLT Clumps
MC-80

All Process in One

All Scenarios in One
Versatile Configurations, Meeting Every Demands









Flexible Compatibility with Varying Layouts and Sample Sizes
Outer L-shaped Layout



Inner L-shaped layout


Pillar Bypassing Module

Long

Short
Turn Module

The turn module can turn the sample racks in another direction.











